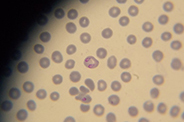

SERVICII Microscopie
Babesioza canina, o neplacere a sezonului cald.
Babesioza canina, o neplacere a sezonului cald.
Babesioza este o boala parazitara determinata de paraziti endoglobulari din fam.Babesiidae transmise prin intermediul capuselor. Babesiile au un ciclu de dezvoltare diheteroxen, mamiferele fiind gazde intermediare, in organismele acestora se dezvolta stadiile asexuate ale parazitului(sporozoiti, trofozoiti, merozoiti).
Babesioza este produsa de Babesia canis cu 3 subspecii(B.c. vogeli, B.c.rossi si B.c. canis raspandita in Europa) si Babesia gibsoni. Pe teritoriul tarii noastre boala este transmisa de capuse din specia Dermatocentor reticulatus. Boala este dependenta de biotipul capuselor si are un caracter zonal si sezonier. Incidenta bolii creste din luna aprilie o data cu aparitia atacului cu capuse si dureaza pana toamna cand au un nou apogeu. Initial zonele babesigene erau delimitate de climate mai calde (mediteraneene) dar odata cu circulatia cainilor alaturi de oameni cat si a raspandirii capuselor aceastea au dobandit un areal nou. Cainii vagabonzi de obicei mai rezistenti la boala pot fii de asemenea o sursa importanta pentru boala. Rasele ameliorate si cainii tineri sunt mai receptivi.
Teste PCR facute pe un lot de capuse din specia Dermatocentor reticulatus arata ca aproximativ 29% din acestea erau purtatoare de babesii(1). Pericolul este evident avand in vedere extinderea masiva in ultimii ani a capuselor atat din cauza incalzirii temperaturii medii anuale cat si a lipsei ingrijirii pasunilor.
Boala poate evolua supraacut, acut, cronic si asimptomatic(in animale purtatoare). Forma acuta se manifesta dupa 2-3 saptamani de incubatie si evolueaza cu apatie, adinamie, febra, anorexie, subicter sau icter si anemie. Unii bolnavi pot manifesta tulburari respiratorii sau nervoase. Morfopatologic pot sa apara splenomegalie, degenerescenta hepatica, subicter, edem cerebral, petesii si infuziuni endocardice, glomerulonefrita. Forma cronica dureaza mai multe saptamani si predomina anemia si cahexia accentuate a animalului.
Nici unul din semnele clinice nu este patognomonic, confirmarea bolii se face de obicei prin frotiuri de sange colorate M.G.G. in care se identifica formele parazitare. Teste care mai pot confirma prezenta parazitului sunt E.L.I.S.A., P.C.R. si I.F.I
Tratamentul se face cu Berenil, Acaprin si Imidocarb, ultimul fiind medicamentul de electie. Se vor face doua administrari 5-6,6 mg/kg la interval de 14 zile pentu a prinde toate stadiile de dezvoltare parazitara. Se vor evita supradozarile deoarece pot determina efecte adverse inclusiv probleme renale si hepatice. De asemenea trebuie facuta o deparazitare riguroasa externa a animalului si preventie a reinfestarii a acestora cu capuse.
Boala poate fi din fericire prevenita prin vaccinare profilactica cu preparate din merozoiti de B.canis( vaccinul Pirodog), dar cea mai eficienta metoda ramane controlul parazitilor externi prin deparazitari periodice.
Vaccinul Pirodog este un vaccin inactivat ce contine antigeni parazitari solubili (SPA) (4). SPA poate fi obtinut din supernatantul unor culturi in vitro de Babesia. Vaccinul nu impiedica 100% aparitia bolii dar ofera conform datelor publicate de cei de la Merial la 75% din cainii vaccinati un titru de anticorpi ≥1/160, dar manifestarile ei vor fii mai usoare.
Protocolul de vaccinare incepe la varsta de 5 luni si se continua cu rapel la 3-4 saptamani. Anual vaccinul se repeta de 1-2 ori in functie de riscul epidemiologic din zona. Vaccinarile au eficacitate mai mare daca se fac inaintea perioadelor de atacuri de capuse: lunile decembrie, ianuarie si sfarsitul lunii iulie spre august(in caz de 2 administrari pe an). La fel ca majoritatea vaccinurilor producatorii recomanda administrarea acestuia doar animalelor in stare de sanatate buna, pe animalele imunosupresate sau cu alte afectiuni eficacitatea vaccinului poate fii redusa. Babesioza da un fenomen clinic de imunosupresie ce dureaza aproximativ 6 saptamani, vaccinarea unui caine ce a suferit de boala se va face la minim 8 saptamani dupa vindecare. Se recomanda a nu se asocia vaccinarea cu Pirodog cu alte vaccinuri decat cel anti-rabic si antileptospiric acestea fiind inoculate in puncte diferite. Alte vaccinari sunt recomandate a fii facute la 2-3 saptamani distanta de acestea.










